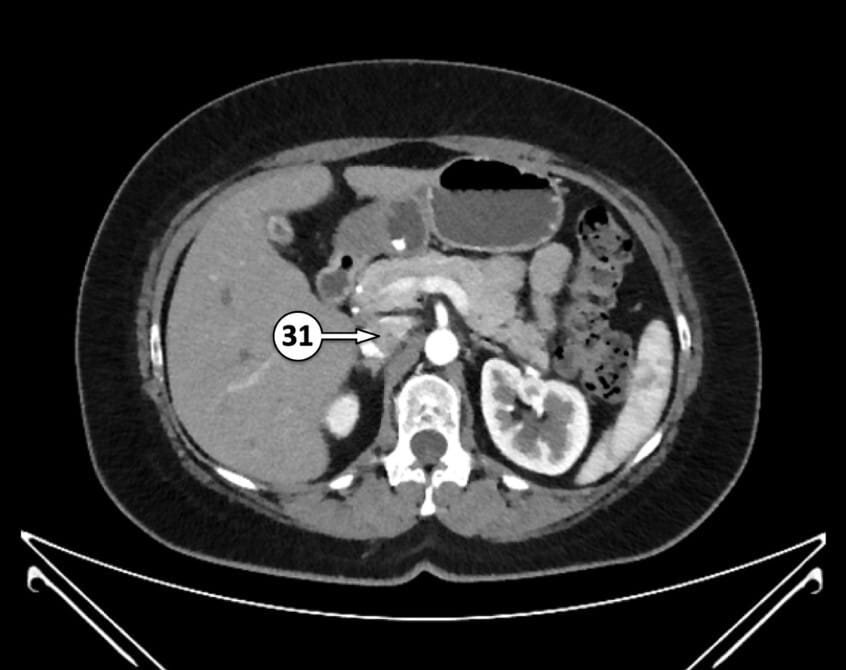
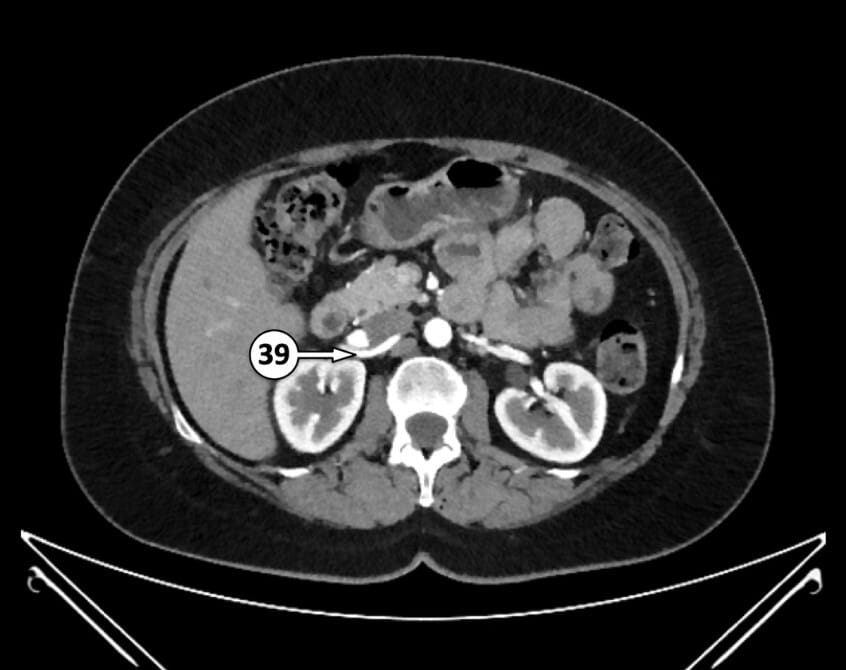
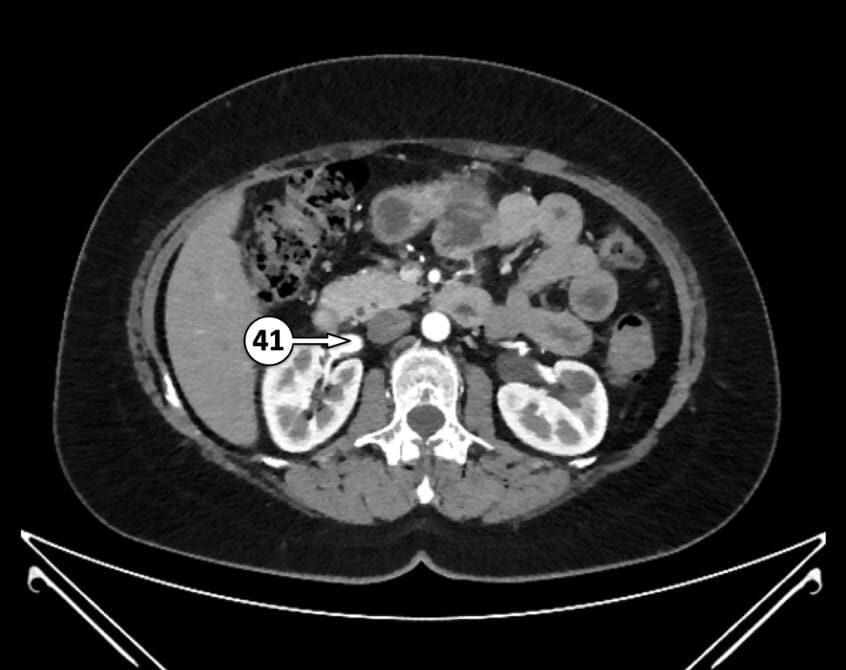
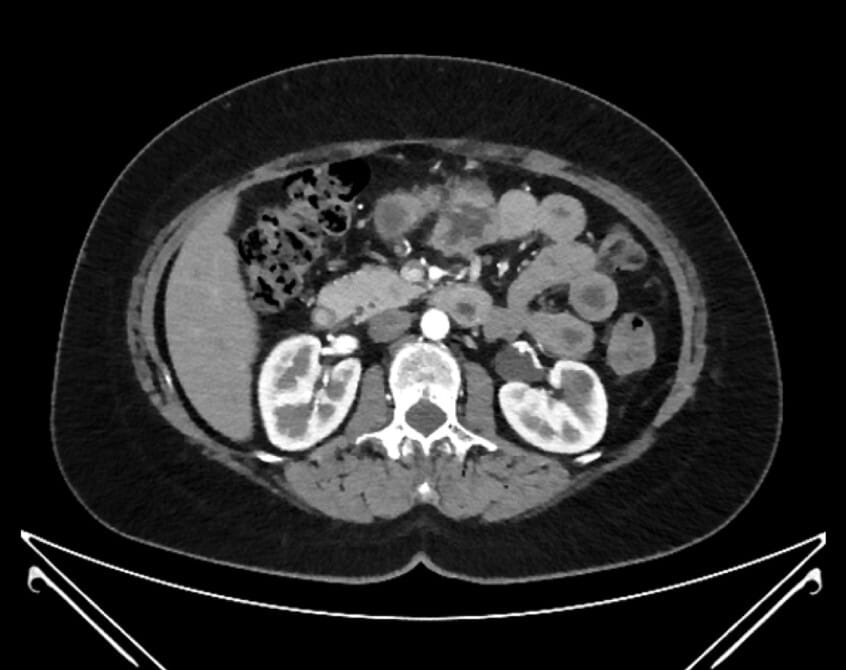

Hacking C, CT angiogram abdomen/pelvis axial – labeling questions. Case study, Radiopaedia.org (Accessed on 14 Jul 2025) https://doi.org/10.53347/rID-94456

1. descending thoracic aorta

2. left atrium

3. internal thoracic (mammary) artery

4. right ventricle

5. azygos vein

6. left ventricle

7. posterior intercostal artery

8. coronary sinus

9. right atrium

10. posterior intercostal artery



11. distal segment of right coronary artery




12. left gastro-epiploic (gastro-omental) artery

13. right hepatic vein

14. intrahepatic segment of inferior vena cava

15. middle hepatic vein

16. left hepatic vein




17. left portal vein

18. left hepatic artery

19. right portal vein

20. superior epigastric artery


21. right hepatic artery

22. splenic artery

23. left gastric artery

24. splenic vein

25. celiac trunk

26. common hepatic artery proper

27. right gastric artery

28. common hepatic artery

29. gastroduodenal artery

30. portal vein
31. suprarenal segment of inferior vena cava

32. superior mesenteric artery


33. left renal artery

34. left renal vein

35. superior pancreaticoduodenal artery

36. right gastro-epiploic (gastro-omental) artery

37. inferior pancreaticoduodenal artery
38. accessory left renal artery (variant)
39. right renal artery


40. superior mesenteric vein
41. right renal vein

42. inferior mesenteric vein

43. right colic artery (shared trunk with MCA, variant)

44. middle colic artery (shared trunk with RCA, variant)

45. left colic artery

46. infrarenal segment of inferior vena cava

47. jejunal artery (one of several)


48. abdominal aorta

49. lumbar artery

50. inferior mesenteric artery








51. ileal artery (one of several)




52. median sacral artery

53. ileocolic artery

54. sigmoid artery (one of several)

55. right common iliac artery

56. left common iliac vein


57. right common iliac vein


58. left common iliac artery


59. ileal artery (one of several)

60. sigmoid artery (one of several)

61. external iliac artery


62. iliolumbar artery


63. internal iliac artery


64. superior rectal artery

65. posterior division of internal iliac artery

66. anterior division of internal iliac artery





67. superior gluteal artery

68. inferior epigastric artery



69. deep circumflex iliac artery

70. inferior gluteal artery (off posterior division of IIA, variant)

71. obliterated umbilical artery

72. inferior epigastric artery


73. superficial circumflex iliac artery

74. aberrant obturator artery (off inferior epigastric artery, variant)

75. internal pudendal artery




76. common femoral artery

77. internal pudendal artery in pudendal canal

78. inferior rectal artery


79. muscular perforator branch of profunda femoris artery

80. superficial femoral artery



81. profunda femoris artery


Table of Contents
Resource
- Hacking C, CT angiogram abdomen/pelvis axial – labeling questions. Case study, Radiopaedia.org (Accessed on 14 Jul 2025) https://doi.org/10.53347/rID-94456

